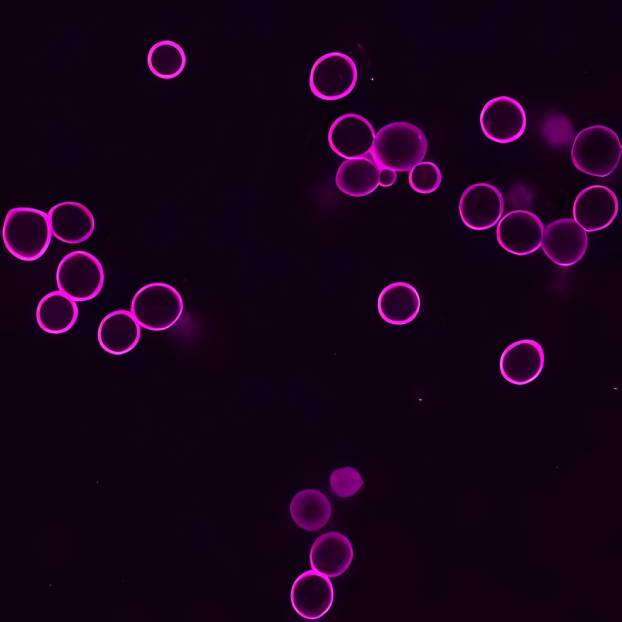

Far-red fluorescent dyes like Cy®5 have long been favored for their sensitivity in detecting minimal autofluorescence in biological samples. Recently, Alexa Fluor® 647 has emerged with brighter fluorescence and enhanced photostability, though it still falls short for some applications. Alexa Fluor® 633, while photostable, exhibits weak protein fluorescence. Addressing these challenges, Biotium introduces CF®633 with advanced chemistry, boasting significantly brighter fluorescence and unparalleled photostability (Figure 2). This makes CF®633 ideal for systems using 633 or 635 nm laser excitation, including TIRF and super-resolution imaging (learn more about CF® Dyes for Super-Resolution Imaging).
See products available with CF®633. Additional reactive dyes or conjugates may be added on request, contact techsupport@biotium.com to inquire.
CF®633 Features
- Brightest far-red fluorescent conjugates
- Excellent photostability
- Highly water soluble and pH-insensitive
- Compatible with TIRF and other super-resolution methods
CF®633 Technical Summary
- Abs/Em maxima: 630/650 nm
- Extinction coefficient: 100,000
- Molecular weight: ~820
- Laser line: 633 or 635 nm
- Alternative for: Alexa Fluor® 633, Alexa Fluor® 647, Cy®5 and DyLight® 649
- Fluorescence lifetime:
τ (ns)/free acid in PBS pH 7.4, ε (ns) = 3.39* (in water)
τ (ns) /S.Ab§ = 3
Lifetime data obtained via customer communication under different experimental conditions and imaging setup.
Visit our FAQ for more fluorescence lifetime information on CF® Dyes.



Helpful Tools & Resources
CF is a registered trademark of Biotium Inc. Alexa Fluor and DyLight are registered trademarks of Thermo Fisher Scientific; Cy Dye is a registered trademark of Cytiva.